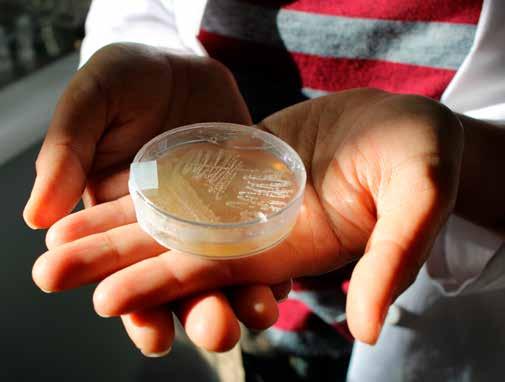

La justicia consideró que el delito tuvo una motivación homofóbica o de desprecio a la orientación sexual de la víctima
El Tribunal Oral en lo Penal de Quillota declaró culpable a Joaquín Correa Olivares, como autor de un robo con homicidio que ocurrió el 30 de julio de 2022 y que tuvo como víctima fatal a Jaime Vergara Jimenez, un conocido chef y profesor de la comuna.
El cuerpo sin vida de Jaime Vergara fue encontrado en un departamento del condominio Altos de Merced de Quillota. La Brigada de Homicidios de Valparaíso efectuó las primeras pericias, informando en aquella oportunidad que el cocinero había recibido múltiples puñaladas, falleciendo por estas graves heridas.
Jaime Vergara era padre y tenía más de 20 años de trayectoria en el rubro
de la gastronomía. Era chef y profesor en el Centro de Formación Técnica de la Pontificia Universidad Católica de Valparaíso, con sede en Quillota, en la avenida Condell.
En el CFT PUCV de Quillota fue Asistente Académico de las carreras de TNS en Turismo y Hotelería y TNS en Gastronomía Internacional.
UN CRIMEN MOTIVADO
POR EL ODIO
Jaime fue injustamente asesinado a la edad de 47 años y la noticia generó conmoción en Quillota, especialmente en la comunidad educativa del CFT PUCV que está en la avenida Condell, donde se realizaron homenajes y jornadas de oración.
El juicio oral tuvo una extensión de tres jornadas, comenzando el miércoles 12 de junio y terminando el viernes pasado, cuando se realizó la lectura del veredicto.
“(La víctima) el día de los hechos tuvo contacto fatídicamente con el acusado, quien inicialmente sólo le iba a entregar una pequeña dosis de marihuana. No
obstante, ingresó a su domicilio y en el interior de su departamento, acometió en contra de la víctima con más de 35 puñaladas en zonas vitales del cuerpo, causándole la muerte a la víctima y no conforme con ello, tomó un plumón y colocó y escribió en la espalda de la víctima la expresión: ‘por maraco'”, comunicó el fiscal jefe de Quillota, César Astudillo. Se aplicó la agravante de la Ley Zamudio en la condena
El fiscal de Quillota, César Astudillo, indicó: “Desde el inicio de la investigación ya nos daba cuenta el perfil del autor de este hecho, como un sujeto frío, que actuó motivado por el odio y la orientación sexual de la víctima. Es así que se rindió la prueba en este sentido y el tribunal acreditó con ella la participación del imputado en los hechos. Y acogió una de las agravantes más poco aplicadas en nuestro sistema, la conocida aplicante de la Ley Zamudio, esto es, que el imputado actuó motivado por odio, desprecio hacia la orientación sexual de la víctima”.
Las pruebas que presentó la Fis -
Bomberos ya habría controlado el siniestro y se produjo un corte de energía eléctrica en el sector
La tarde de este lunes, unidades de Bomberos y equipos de emergencias trabajan en un incendio estructural que afecta a uno de los edificios de departamentos KPD, de Avenida Los Carrera esquina Cumming, pleno centro de Quilpué.
Tras la alerta de fuego y humo que salía del cuarto piso de uno de los edificios, hasta el lugar concurrieron 3 máquinas del Cuerpo de Bomberos de la comuna, quienes habrían controlado el origen del incendio, el cual afectó el entretecho de dos departamentos y el pasillo del cuarto
piso del edificio.
De manera preventiva, Chilquinta realizó un corte del suministro eléctrico, para el trabajo de los equipos de emergencia y se hizo la evacuación preventiva de los habitantes del edificio.
Cabe mencionar que por redes sociales circularon diversos videos dando cuenta de esta emergencia, que puedes revisar a continuación:
calía fueron la base que generó, en el tribunal, la convicción de la culpabilidad del imputado. Entre las pruebas expuestas, están los testimonios de funcionarios de la Brigada de Homicidios de la PDI, registros audiovisuales, testimonios, pruebas de ADN y un peritaje psiquiátrico que se le hizo al acusado.
El próximo miércoles 19 de junio se dará a conocer la sentencia, que detallará la pena que recibirá el condenado. El Ministerio Público solicitó que se dicte presidio perpetuo por este crimen.


El establecimiento se transformará en un espacio moderno, seguro e inclusivo a partir de una inversión de $405.285.21 con fondos de Conservación de Infraestructura del Ministerio de Educación
El pasado miércoles 12 de junio se realizó la ceremonia del Colegio Lo Rojas “Memoranzas de nuestro colegio”, dando inicio a las vacaciones de las y los estudiantes y también al Proyecto de Conservación de Lo Rojas que tiene como objetivo la remodelación y mejoramiento del establecimiento. Durante el Concejo Municipal realizado el pasado 16 de mayo, la alcaldesa de La Cruz, Filomena Navia Hevia junto al Honorable Concejo, aprobaron la adjudicación de la contratación de la empresa que está a cargo del Proyecto de Conservación de la Escuela Lo Rojas.
Este proyecto es un trabajo colaborativo entre la Secretaría Comunal de Planificación (SECPLAN) y el Departamento de Administración Educacional Municipal (DAEM). Con un monto de $405.285.21 a partir de fondos de Conservación de Infraestructura del Ministerio de Educación, permitirá transformar el establecimiento en un espacio moderno, seguro e inclusivo.

Este proyecto contempla el mejoramiento de las fachadas, el cambio de cubiertas, ventanas existentes por ventanas termo panel, puertas, pisos y cielos, mejorando el acondicionamiento térmico de la escuela. Además, contempla la implementación de las normas de accesibilidad universal completa para el establecimiento, implementación de un nuevo sistema de alcantarillado particular para baños y cocina e implementación de una nueva red eléctrica para circuito de enchufes y alumbrado. El cambio de cubiertas contempla la utilización de E-Kover Pol el cual mejora la aislación térmica y acústica. El mejoramiento de la fachada y revestimiento interior contempla la utilización de Siding Fibrocemento incorporando la aislación térmica al interior de los muros y mejorando la aislación térmica y acústica. Para el recambio de las puertas y ventanas se
utilizará Termopanel y para el recambio de pisos el Porcelanato Antideslizante para mayor seguridad. El proyecto también considera la accesibilidad universal de todas las salas del establecimiento educacional, eliminando los peldaños en los accesos e incorporando rampas para dar accesibilidad a todas y todos los estudiantes del recinto. El nuevo sistema de alcantarillado particular considera su renovación con fosa y pozos absorbentes renovados, cumpliendo con las exigencias del Ministerio de Salud. Por otro lado, la nueva red eléctrica considera un la renovación del tendido eléctrico, tanto para circuitos de alumbrado, como los circuitos para enchufes. Incluye nuevas luminarias led de bajo consumo, mejorando las condiciones de iluminación al interior de las salas de clases.



Recinto asistencial actúa de manera proactiva ante posibles requerimientos de hospitalizaciones que signifiquen cuidados críticos
El Hospital Biprovincial Quillota Petorca se antepone al posible requerimiento de camas para pacientes críticos. Esto en el marco del peak de la circulación viral por Influenza, el aumento de consultas respiratorias en la Unidad de Emergencias y cuando aún faltan muchas personas que atiendan la campaña de vacunación contra la influenza, en grupos objetivos como adultos mayores de 65 años y embarazadas.
Es así como este lunes 10 el recinto decidió que 4 camas de la Unidad de Cuidados Intermedios, UTI, se reconvierten a Cuidados Intensivos; lo que, además, implicó que en el área de Médico Quirúrgico Adulto, 3 camas pasen a ser de Cuidados Medios para la recuperación y salida de pacientes UCI.
Así lo explicó el Director del Hospital Biprovincial, Haroldo Faúndez Romero, que destacó que ésta es un de las estrategias proactivas que venía madurando el establecimiento para hacer frente a la contingencia de salud.
. “Esta es una de tantas estrategias que se vienen trabajando desde la ex-
periencia de años anteriores. Una de ellas es esta de reconvertir camas intermedias a Cuidados Intensivos; es decir, estamos ofreciendo mayor complejidad, que en definitiva es donde repercuten estos contagios y enfermedades respiratorias cuando se requiere hospitalización. Asimismo, estamos poniendo a disposición 3 camas médico quirúrgicas más que nos permiten hacer flujo de estas camas UCI pero, como digo, esta es una de varias estrategias que se están adoptando”, sostuvo el directivo.
Esta reconversión de camas, es además una estrategia de gran compromiso por parte del personal de salud que asume este desafío y así lo destacó el Dr. Roberto Contreras Aguilera, Jefe de la Unidad de Paciente Crítico del Hospital Biprovincial:
“En primer lugar, lo que se requiere en estos casos es tratar de aumentar nuestra capacidad de respuesta de camas críticas de Cuidados Intensivos y, en ese sentido, nosotros como institución hemos hecho el esfuerzo de reconvertir 4 camas de intermedio a camas de UCI. En realidad, es un tra-

bajo enorme que estamos enfrentando como Unidad, a nivel multiestamental, todo el personal que está encargado del manejo tanto en la fase aguda como en la rehabilitación del paciente, y hasta el momento hemos tenido buenos resultados, tenemos cero mortalidad en cuanto a pacientes con neumonía grave por influenza, y esperamos que ello se mantenga así”, argumentó el médico intensivista.
Desde el recinto informaron que si bien la influenza está en pleno peak, este virus debiese iniciar un descenso, con ello nuevos virus asumirían el protagonismo como el Virus Respiratorio Sincicial, el metapneumovirus,
la parainfluenza y otros que seguirán presionando a la red asistencial. De igual forma, otra de las complicaciones de esta época es que aquellos pacientes que tuvieron influenza quedan con su sistema inmunológico un poco deteriorado, lo que puede ocasionar neumonías bacterianas y complicaciones en la salud de este grupo. Es por ello que para hacer frente a esta contingencia por patologías invernales, en estos días el Hospital Biprovincial dará inicio formal a la Campaña de Invierno 2024, con diversas estrategias para poder dar respuesta a las comunidades de las provincias de Petorca y Quillota en este periodo invernal.
Castillos y edificios de arena
Las dunas en el litoral no son simplemente cerros de arena para jugar o escalar. Es posible que estas dunas se hayan formado a través del tiempo y acumulen miles de años de historia, dunas que se han conformado a través de sedimentos transportados o removidos por la acción del viento, cumpliendo así un papel importante en la protección de zonas costeras habitadas y en la mantención del equilibrio ecológico.
Las dunas actúan como una cortina, un muro natural entre el océano y el continente. Se trata de una especie de construcción propia que evita el impacto natural, aminorando los temporales y las crecidas del mar, adicionalmente filtran agua y recargan las napas freáticas. Son el hábitat de plantas y animales; también funcionan como reservorios para proveer de arena a las playas cuando éstas van deteriorándose. Las dunas pueden ser activas e ir cambiando de forma con el tiempo o bien pueden ser estables, gracias a una capa vegetal que impide el desplazamiento de la arena.
Hoy asociamos la construcción de edificios en campo dunar con los socavones. Un socavón se forma en una duna cuando las capas ya no pueden soportar los sedimentos superficiales que se suspenden sobre el vacío dejado por la erosión. Por lo general, apenas se notan los cambios en la superficie. Un socavón es una cavidad
EMPRESA PERIODÍSTICA EL OBSERVADOR
Fundador y Presidente del Directorio:
Roberto Silva Bijit
Director:
Roberto Silva Binvignat
Jefe de Informaciones: Gabriel Abarca Armijo
La Concepción 277 - Quillota www.observador.cl
PUBLICIDAD
Coordinadora Comercial:
Verónica Tapia Herrera ventasquillota@observador.cl
Fono: +56 9 8887 9747Casa Matriz - Quillota

o agujero que se forma en la superficie terrestre, generalmente debido a procesos de erosión, colapso o hundimiento del terreno. Hay varias causas que pueden contribuir a la formación de socavones. El impacto producido -entre otros motivos- por el cambio climático y la mano del ser humano, produce erosión costera en las playas y en los litorales arenosos, los que presentan disminución, menor presencia y retroceso; por lo tanto, eso limita la construcción sobre dunas.
Al presentarse la reducción de la playa y al afectarse con construcciones masivas, el desarrollo y la dinámica natural que requieren las dunas primarias, se genera un retroceso y una degradación de todos los ecosistemas vinculados al campo dunar. Ello genera un retroceso y disminución de las arenas que deben ser movilizadas por el viento para formar otras dunas.
Construir sobre dunas representa un riesgo para nuestro hábitat: las dunas, al tener una dinámica móvil, no resisten una excesiva carga de construcciones que aplastan y cambian su naturaleza dinámica y su esencia de sistema perfecto.
No sólo los castillos de arena se caen con el devenir del viento. También los edificios construidos con ladrillo y hormigón en dunas de arena, por cuanto no han considerado suficientemente los secretos que entrega la naturaleza.
El cáncer de mama es una realidad que afecta a muchas mujeres en Chile y el mundo. Tras enfrentar esta enfermedad, la reconstrucción mamaria representa una oportunidad invaluable para la recuperación física y emocional de las pacientes.
Sin embargo, el primer registro de mujeres en espera de reconstrucción mamaria, realizado por el Observatorio del Cáncer en Chile, evidenció que el 62% de las mujeres mastectomizadas no cuentan con información sobre los requisitos para acceder a esta intervención. Esta falta de información, sumada a las diferencias en el acceso entre los sistemas público y privado de salud, genera sentimientos de incertidumbre y abandono en las pacientes. Para abordar esta situación, es fundamental que todos los actores del sistema sanitario colaboren y trabajen en conjunto.
Es necesario implementar políticas públicas que garanticen un acceso equitativo a la reconstrucción mamaria, así como campañas de información y sensibilización que empoderen a las mujeres con conocimiento sobre sus opciones y derechos. La incorporación de la reconstrucción mamaria a la canasta GES desde 2010 ya fue un avance que no puede quedarse sólo en eso. La reconstrucción mamaria es una herramienta valiosa en el camino hacia la recuperación integral de las sobrevivientes de cáncer de mama.
Francisco Cabezas
“Es preocupante la laxitud de la cancillería frente al tema argentino, que es preocupante. Con Argentina somos naciones hermanas, pero los hermanos también tienen problemas. Sobre todo cuando se trata de repartirse bienes. Dicen que a los hermanos uno los conoce en la herencia”.
Oscar Aranda, ex director de Inteligencia de la Armada (Ex Ante, 14 de junio 2024)

“Es razonable que se reconsidere si mantener las platas en las AFP”
Gonzalo
Winter Diputado (CS)“A la gente se le dice que mantenga su plata en las AFP porque habrá un sistema de pensiones, gran parte de esa espera es porque habrá un nuevo sistema de pensiones, pero si se entera de que se va a mantener el actual sistema de pensiones y que va a ganar la propuesta de la derecha, que es no subir las pensiones, entonces yo entiendo que es razonable que la ciudadanía reconsidere si quiere mantener su plata ahí o no” (cnnchile.com, 11 de junio 2024)

“No es una buena idea”
Paulina Vodanovic Presidenta PS
“Concuerdo con los efectos económicos que tuvieron los retiros anteriores. No es una buena idea ni para la economía ni tampoco para las personas (...). Pero, frente a la intransigencia de que se avance en una solución definitiva en materia de pensiones, por una falta de capacidad de llegar a acuerdos de la derecha (...), es comprensible que empiecen a aparecer estas posiciones de decir ‘si no hay solución, entonces, vamos con los retiros’”. (La Tercera, 14 de junio 2024)
Invitamos a nuestros lectores a enviar sus cartas al correo mvaldes@observador.cl

Everton y Barnechea
serán los respectivos rivales
El sistema frontal, que con fuerza afectó a la Región de Valparaíso y al centro del país, llevó a que los dirigentes de la ANFP decidieran reprogramar varios partidos de la Copa Chile que se debían jugar a partir del viernes y durante el fin de semana. Y uno de los encuentros que se vio afectados por esta medida fue el de San Luis de Quillota. Los canarios debían jugar la noche del viernes a contar de las 19:00 horas frente a Everton de Viña del Mar, partido que se jugaría en el Estadio Lucio “Fariña Fernández”.
Sin embargo, dicho encuentro fue reprogramado para mañana martes

18 de junio en el mismo horario y estadio, pero quedando la incertidumbre si dicha jornada deportiva se podrá realizar debido a que nuevamente se anuncian lluvias para nuestra zona a partir de hoy por la noche.
También se decidió reprogramar el partido de Deportes Limache, que en un comienzo se jugaba el domingo a contar del mediodía en el Estadio “Nicolás Chahuán Nazar”, donde los rojos debían enfrentar al conjunto de Barnechea.
Dicho partido finalmente se disputará hoy lunes a contar de las 19:00 horas en el reducto calerano, recordando que en esta fase de la Copa Chile son partidos únicos, por lo que si hay empate al final de los 90 minutos, el elenco clasificado a la fase siguiente se define mediante los lanzamientos penales.

Ingeniero en construcción advierte: “No debería inundarse un lugar dos años seguidos y está pasando”
A raíz de las intensas lluvias ocurridas durante los últimos días, profesor de la PUCV entrega análisis de cómo deberían resistir las ciudades el paso de un sistema frontal de gran envergadura
Las fuertes lluvias que se dejaron sentir en la zona central una vez más mostraron la fragilidad de nuestras ciudades en torno a posibles colapsos en sus principales arterias. Y si bien la zona central resistió de buena manera el temporal, igual se presentaron los típicos anegamientos en pasos bajo nivel y en caminos de conexión de diversas comunas, lo que hace pensar que las ciudades no están preparadas para recibir este tipo de fenómenos climáticos.
Para el ingeniero constructor y profesor de la Escuela de Ingeniería de Construcción y Transporte de la Pontificia Universidad Católica de Valparaíso, Luis López, “las ciudades se diseñan, construyen, operan y mantienen previniendo acciones climáticas sobre ellas, por tanto teóricamente sí están preparadas para este tipo de eventos. Sin embargo, esta
preparación no evita que el evento, que pone prueba toda la infraestructura pública y la preparación, produzca situaciones de falla de algunos puntos”.
López agregó que “en las zonas de inundación el problema suele ser una mala fiscalización y lentitud en procesos de evitar y trasladar a las personas que se asientan en zonas inundables, una mantención deficitaria de los colectores, diversas modificaciones realizadas por terceros, falta de dinero o lentitud en reparaciones”.
Por otra parte, el ingeniero constructor agregó que “en general el
diseño, construcción y operación de los sistemas de drenaje urbanos funcionan bien, sin embargo, estamos fallando en evitar la construcción en lugares inundables y en solucionar los casos particulares, tanto los que no han funcionado bien, así como también los identificados no reparados. No debería inundarse un lugar dos años seguidos y está pasando”.
Por último el profesor de la Escuela de Ingeniería de Construcción y Transporte de la PUCV, detalló que “actualmente se considera el crecimiento urbano, los planes de desarrollo comunal, los planes maestros
de agua lluvias, las estadísticas climáticas, hidrología, hidráulica, mecánica de suelos etc. Sin embargo, en la práctica, vemos que en los eventos siguen fallando las estructuras. Me parece que en aquellos lugares más frágiles, se debe realizar el diseño pensando en la falla y los efectos que esta produciría; esto se hace en otros sistemas de ingeniería. Probablemente este tipo de diseño incrementará los costos, por cambios de trazado, aumento de diámetros o aumento del costo de suelo, entre otros, pero evitará en esas zonas los problemas que estamos visualizando estos días”.

Banda ya estaba en el ojo del Ministerio Público por haber protagonizado otro hecho similar en Quilpué
Un robo con intimidación, protagonizado por una banda de tres menores de edad, afectó a un adolescente que transitaba a eso de las 16:30 horas de este sábado por calle Victoria, en la comuna de Villa Alemana. El violento atraco quedó registrado en una cámara de televigilancia, lo que permitió identificar rápidamente a los atacantes que, de manera cobarde, abordaron con un arma de fuego y un cuchillo al menor que caminaba tranquilamente y a plena luz del día en la calle.
Fue Osvaldo Basso, fiscal jefe de Villa Alemana, quien informó que los sujetos le exigieron sus pertenencias de valor a la víctima, lo redujeron y “le robaron un celular, un cinturón, un jockey, billetera y otras especies, por lo que huyeron rápidamente del lugar”.
Afortunadamente, una vecina ayudó al muchacho, llamó a Carabineros y aportó videos con las imágenes del robo. Los tres menores protagonistas del ataque pasaron a control de detención el domingo y quedaron sujetos a la medida de internación provisoria por un plazo de 60 días.
A uno de los imputados se le encontró el jockey y una cadena de la víctima, mientras que en las casas de los otros dos jóvenes -que resultaron ser hermanos- se les encontró el celular y el cinturón.
Según el fiscal Basso, los hermanos habían protagonizado otro delito similar en Quilpué. Como el trabajo del trío iba en escalada, el tribunal
optó por la medida más gravosa para los imputados, ya que consideró que los menores eran “un peligro para la seguridad de la sociedad”.

Sujeto ingresó a un domicilio para robar una serie de joyas y especies, pero los policías lo lograron ubicar, ya que tenía orden de aprehensión vigente y un amplio prontuario.
En un óptimo operativo policial, luego que se le diera alerta a los Carabineros de la 6ta Comisaría de Villa Alemana, los funcionarios del turno lograron detener a un sujeto que en horas de la noche del viernes pasado ingresó a una vivienda para robar una serie de especies. El individuo no contó que el lugar mantenía cámaras de televigilancia, por lo que este registro fue clave para identificar al antisocial que ingresó con un gorro, guantes y una serie de herramientas para forzar los accesos y realizar sus fechorías.

En concreto, el delincuente logró robar joyas, un celular y otras especies de valor, por lo que fue detenido por funcionarios policiales. Lo increíble es que al tomarle los datos,
Carabineros se percató en el sistema que el sujeto contaba con una orden de aprehensión vigente por quebrantamiento de condena.
Además, el ladrón mantenía 15
condenas previas, ocho de ellas reiteraciones de los delitos de robo de vehículo y a domicilios, por lo que fue conducido al tribunal para enfrentar la acción de la justicia.
Se robaron unos $3 millones en pañales y varias especies de valor desde inmueble que se ubica en calle Pudeto 712
Impactadas se sienten las 36 voluntarias de las Damas de Rojo de Quillota, quienes al momento de ingresar a su sede que se ubica en calle Pudeto 712 se encontraron con los accesos rotos, un desorden total y el robo de unos $3 millones en especies.
Fue María Angélica Espejo, presidenta de las Damas de Rojo de Quillota quien contó a Observador.cl detalles del ataque a la sede que ocurrió en horas de la noche de este fin de semana. Todo indica que el sábado 15 de junio.
“Nosotros ayudamos a muchas personas en el hospital y nos cuesta mucho. Ahora había una compra con la plata de la colecta, con dineros que rendimos hasta el último peso. Se compraron útiles de aseo, pañales y todas las cosas que donamos a los pacientes. Nos robaron todo en la sede”, explicó la presidenta.
Una cocina, estufa, equipo de comunicaciones, hervidores, loza y muchas especies. “Fueron más de $3 millones en total. Es demasiada la maldad”, lamentó la voluntaria.
Hay que tomar en cuenta que las Damas de Rojos realizan hace 48 años su labor en la comuna, entregan una muy importante ayuda con insumos como pañales y útiles de aseo a los pacientes crónicos del antiguo Hospital San Martín y el actual Biprovincial. Ahora tendrán que reforzar las medidas de seguridad de la vivienda que les presta el Club de Leones y en donde funcionan hace unos 10 años.
Finalmente, María Angélica hizo un llamado a las personas de buena voluntad y empresas de la zona a que la contacten, para entregar ayuda, ya que la sede se quedó sin elementos


básicos como para poder funcionar con normalidad, especialmente para atender al público y el trabajo de las voluntarias.
“Ojalá la comunidad nos coopere con una cocina usada, o lo que sea. Realmente lo necesitamos”, solicitó la presidenta de esta querida institución de la comuna.
Quienes puedan colaborar pueden contactarse al teléfono de María Angélica Espejo: +569 87574717.

Por solicitud de Serviu, destacada casa de estudios superiores se hizo cargo del trabajo de investigación en terreno de las causas de la emergencia, en área del edificio Euromarina II de Reñaca.

La Pontificia Universidad Católica de Valparaíso (PUCV) se hizo cargo de los peritajes e investigaciones tendientes a dilucidar por qué se produjo el socavón el fin de semana del sábado 8 y domingo 9 de junio, bajo el edificio Euromarina II de Reñaca.
Para tal efecto, el pasado sábado 15 se realizó una reunión de coordinación entre los profesionales de Serviu, encabezados por su director regional Rodrigo Uribe, y el equipo a cargo de la casa de estudios superiores, tras lo cual comenzaron las faenas iniciales del peritaje en el mencionado edificio.
Al respecto, se refirió el director regional del servicio, quien destacó esta acción se suma al resto de las medidas de mitigación que ya se han implementado.
“Seguimos trabajando en el área del socavón de Viña del Mar. Estamos con un equipo ya instalado dentro de las diversas medidas que estamos tomando, tanto de mitigación. Corresponde también un peritaje, que ya fue anunciado. Ya está el equipo de la Pontificia Universidad Católica de Valparaíso trabajando en terreno y desplegado, para poder dar cuenta de las causas de este socavón en Viña del Mar”, explicó el director regional de Serviu.
PROTECCIÓN DEL SOCAVÓN
En paralelo a los peritajes, profesio -
nales de Serviu Valparaíso se mantienen 24 horas atentos a la evolución del caso, realizando turnos en terreno y manteniendo permanente contacto con la empresa que realizó el sellado de la calle Las Perlas con asfalto y membrana. Dentro de los trabajos ya realizados, hoy domingo se instaló preventivamente una lámina de polietileno en toda la zona segura de la superficie del socavón -un 70% del total-, cuyo objetivo es evitar que ingrese agua durante las próximas lluvias y continue socavando el terreno.
RETIRO DE ARENA
Junto con lo anterior, desde el viernes se mantiene operativo un sistema de turnos de vehículos pesados para la recolección de arena, a objeto de ir en directa ayuda de los vecinos que recibieron descarga de agua y arena durante el peak de agua caída del último sistema frontal.
De este modo, hasta este domingo se habían retirado 500 metros cúbicos de arena, tanto de las zonas aledañas al edificio Euromarina II, como de los edificios EuroVista y EuroCochoa, los dos últimos ubicados en avenida Borgoño, sector de Cochoa. Dichas labores de retiro de material continuarán este lunes y hasta que se termine la faena.



Una tarde fría y mi dron, a una altura de 200 metros, toma esta foto que muestra todo el humo de las estufas, que antes de llegar el frío del invierno, intentan abrigar sus hogares a como de lugar. Como personas, buscamos la comodidad. Como ambientalistas, mejor soportamos el frío.

Luis Roco, dronero y Relacionador Público Profesional del DuocUc. Fotografía y Video Aéreo, Proyectos Audiovisuales y más. W: +569 8609 0696. Instagram: @luis_roco
“Cuando las cosas no se hacen bien, vemos lo que ocurre con los socavones que hemos visto”
Senador Lagos Weber analiza alternativa de una ley de costas que actualice la actual normativa y delimite las construcciones en el borde costero
Tras moderar uno de los paneles dedicados a abordar la legislación vigente en materia de zonificación costera, desarrollados durante la conmemoración del Día del Océano, en el Congreso de Valparaíso, el parlamentario se reunió con una de las expositoras en la instancia para profundizar en materia de legislación y analizar la posibilidad de establecer una ley de costas que actualice la normativa y establezca límites para la construcción en el borde costero. “Existe una ley de concesiones marítimas que, claramente, necesita un mejoramiento o un enfoque totalmente distinto”, señaló.
A partir de uno de los paneles reconversación que se estableció en el evento en conmemoración del Día del Océano, y que se realizó hace unos días atrás, en la sede Valparaíso del Congreso Nacional, el senador por la región de Valparaíso, Ricardo Lagos Weber, retomó la temática de la legislación vigente en materia de zonificación costera y analizó algunos elementos que se abordaron como parte del debate en la exposición titulada: “La Zona Costera: causas, brechas y avances hacia una gestión integrada de la costa en
Chile”, en la cual participaron investigadores y académicos para analizar la posibilidad de actualizar la Política de Borde Costero que mantiene nuestro país, considerando elementos de aporte científico para el resguardo de nuestras costas, y para lo cual, se ha propuesto desde la academia y diversas organizaciones la creación de una ley de costas que contemple estas materias y pueda delimitar la construcción inmobiliaria en el borde costero.
Según el parlamentario, “tuvimos la semana pasada, a propósito del Día del Océano, un panel donde participó la profesora Carolina Martínez, en el cuál la pregunta fue qué hacemos para regular la zona costera, entendiendo que tiene que conversar el límite marítimo con la zona costera. Hay una interfaz ahí, y Chile tiene una legislación que, tal vez para los años 60 era buena, pero que hoy día no responde, donde vemos que existe una brecha muy difícil de abordar, además, existe un deterioro enorme de esas áreas en su conjunto, y en la cual existe una ley de concesiones marítimas que, claramente, necesita un mejoramiento o un enfoque totalmente distinto, y además, cuando las cosas no se hacen bien, vemos lo que ocurre con los socavones que hemos visto, cuando no se considera a la ciencia como un elemento importante a la hora de otorgar permisos y definir una forma de desarrollo adaptado al borde costero”, señaló.
A su juicio, Lagos Weber agregó que “hoy día, lo que me plantea y de lo que



está preocupado el Observatorio de la Costa UC, es básicamente de lo que conocemos como borde costero, pero que debería llamarse zona costera, que exista una conversación entre ambos lados (límite marítimo y zona costera), y no preocuparse sólo de la línea de playa o borde costero, porque eso sería limitar demasiado esa conversación”, apuntó. “tenemos bastante esperanza en la actualización de la Política de Borde Costero, pero sabemos que también hay que esperar que se apruebe. Nosotros tuvimos la mala suerte de tener una interpretación de un concepto científico en una política nacional que tiene dos elementos claves, que es el uso y el borde, y eso durante 30 años nos ha jugado una muy mala pasada porque estamos zonificando nuestro borde costero considerando las playas erosionadas. Nuestro borde costero consta no más allá de 200 metros (desde la línea de playa), pero también, erosionándose constantemente porque no llegan nutrientes y porque los ecosistemas se degradan, y porque además, el con-

cepto de línea de playa permite que ese deslinde quede estático por tantos años, que termina utilizándose como un instrumento de planificación (erróneamente), tanto es así, que eso permite que proyectos como San Alfonso del Mar, en Algarrobo, o Punta Piqueros en Concón, se pongan en las rocas, junto a tanta urbanización que está desbocada debido a una falta de regulación”, comentó la académica UC.
En este sentido, Martínez aclaró que “nuestra causa de fondo no la puede resolver una política, y esa es la diferencia con otros países que tienen gobernanzas exitosas porque ese dominio público está reconocido como parte de las leyes orgánicas, pero no quedan indicadas a la buena voluntad, como sí podría quedar en caso de aplicarse la actualización de la Política de Borde Costero sin resolver, porque para poder ordenar este dominio público, necesitamos una ley de costas que tiene una impronta en el Presidente (Boric) y debe tener una votación importante en el Senado”, explicó.



La Dra. Fernanda Claverías de la USM es la encargada de caracterizar este nuevo grupo bacteriano que se extrae directamente de la playa Las Torpederas en Valparaíso. Su biodiversidad no se ha registrado en ningún otro lugar del mundo.
En un esfuerzo por fortalecer el papel de las familias como primer agente educativo en la vida de sus hijos e hijas, la División de Organizaciones Sociales de la Seremi de Gobierno de Valparaíso impartió una serie de charlas sobre Formulación, Evaluación y Rendición de Proyectos Sociales. Estas charlas, organizadas por la JUNJI Región de Valparaíso y la Corporación Municipal de Quilpué, se enfocaron en brindar a los apoderados las habilidades necesarias para concretar sus sueños en cuanto a los espacios educativos de sus hijos e hijas.
Según investigaciones en neurociencia educativa, la participación activa de los padres en la educación de sus hijos no solo fortalece el vínculo entre la familia y la institución educativa, sino que también tiene beneficios significativos para el desarrollo integral de los niños y niñas. Un estudio realizado por el Instituto de Neurociencia Cognitiva y Afecti -

va de la Universidad de California, Berkeley, encontró que cuando los padres se involucran en la educación de sus hijos, se activan áreas clave del cerebro relacionadas con la motivación, el aprendizaje y la regulación emocional, lo que resulta en un mejor rendimiento académico y una mayor autoestima.
Vanessa Tudela, apoderada del jardín infantil “Girasoles de Limache”, compartió su experiencia: "La verdad me pareció una muy buena iniciativa el poder acceder a estas tres sesiones
donde pudimos comprender mejor lo que significa el tener un centro de padres tanto para Junji como para el jardín mismo. Creo que fue una muy buena oportunidad para los apoderados, poder integrarse más y ser más partícipe en lo que es la educación de nuestros hijos".
La realización de estas capacitaciones fue valorada por Beatriz Lagos, Directora Regional (s) de la JUNJI, quien destacó el compromiso y el valor de la participación ciudadana: "Esta actividad, coordinada por el
área de Participación Ciudadana de la JUNJI, refleja el compromiso de las familias por construir un mejor futuro para sus hijos. La participación activa de los apoderados en la educación de sus hijos es fundamental para el desarrollo integral de los niños y niñas". Estas iniciativas no solo fortalecen el vínculo entre las familias y las instituciones educativas, sino que también empoderan a las comunidades para crear entornos más enriquecedores y acogedores para las generaciones futuras.
agricultores y alza de precios por lluvias: “Nunca faltan los especuladores”
Antonio Walker señaló que los daños a la agricultura podrían acercarse a los 200 millones de dólares
Severos daños en la agricultura causó el sistema frontal que afectó al país desde Coquimbo a El Maule durante esta semana, lo que ha levantado alertas en cuanto a que esto podría producir eventuales alzas en los precios de los productos agrícolas. Sin embargo, desde el gremio explicaron que esto no debiera producir incremento en los precios, ya que en
muchos casos las cosechas ya están hechas.
Al respecto, Antonio Walker, presidente de la Sociedad Nacional de Agricultura (SNA), señaló a EMOL que “no deberíamos tener un aumento de precios en los alimentos”. Esto, aclaró, debido a que “el daño mayormente puede estar en hortalizas, que es lo que estamos cosechando actualmente y vemos que los precios responden a oferta y demanda. Y hoy día estamos con mercados bastante bien abastecidos”.
Sin embargo, el dirigente puntualizó que “nunca faltan los espe -
culadores, hay que tener cuidado con eso” agregando además que, una vez finalizado el temporal -que en algunas regiones aun persiste- se deberá realizar una cuantificación de daños, cifra que podría bordear los 200 millones de dólares.

No obstante, destacó que “los daños que tenemos esta temporada no tienen nada que ver, hasta el momento, con los dos temporales que tuvimos el año pasado”. A pesar de ello, reconoció que el rubro va a requerir apoyo, por lo que solicitarán “ayuda fundamentalmente financiera para poder de pie a muchos agricultores que están sufriendo las inclemencias de este temporal”. En ese sentido, comentó que “las transferencias directas, el financiamiento, es la mejor ayuda que puede disponer un Gobierno para los sectores dañados”.
Comediante tuvo su tercera aparición en el programa “Podemos Hablar” de CHV. Frente a ello, Margarita Osorio “le paró los carros” en sus redes sociales
La vuelta del personaje Yerko Puchento, del actor Daniel Alcaíno, ha dado que hablar. Esto ya que, en el programa “Podemos Hablar” que conduce el periodista Julio César Rodríguez, no deja títere con cabeza. En su tercer show en este espacio, el deslenguado “comentarista” de la actualidad nacional lanzó sus dardos contra la alcaldesa Margarita Osorio, quien protagonizó una semana en la palestra tras cerrar la sesión del Concejo Municipal al no querer enfrentar situaciones de supuesto acoso laboral en el contexto de la muerte del director de la DOM que se quitó la vida.
“Ahora aparece la alcaldesa de Nogales que es más chora que Martín Vargas, la vieja. A chuchada limpia contra los concejales. Eso no se hace. La Paty Cofré es una alpargata al lado de esa vieja. Hasta Dj Méndez habla

más claro que esa señora”, manifestó el personaje.
Conectado con lo anterior, el comediante fue enfático y mandó un mensaje para todos los postulantes a las próximas municipales: “No más alcaldes que apitutan a sus familiares en todos los cargos. No más alcaldes que no tienen ni cuarto medio. No más alcaldes que dicen ‘gánate’, ‘la calor’ o ‘tenimos’. Y sobre todo, no más alcaldes que por tener un cargo de poder se les da la autoridad para hacer los que se les pare la raja” (SIC).
Al cierre de su monólogo fue categórico: “Llegó la hora de decirles ladrones a los alcaldes ladrones, corruptos a los alcaldes corruptos y

sinvergüenzas a los alcaldes sinvergüenzas”.
FUERTE RESPUESTA Y MOLESTIA
Molesta reaccionó la alcaldesa Margarita Osorio a los dichos de su persona en CHV. La autoridad comunal utilizó su Facebook personal para manifestar su enfado con el comediante, en su particular estilo y sin mediar en correcciones ortográficas. “YERKO. copuchento no te fundas hablando huevadas en el canal CHV…
hablando que yo trato a garabatos a los concejales en el consejo municipal. Usted tiene pruebas” (SIC), detalló. Por último, agregó que como persona Daniel Alcaíno tiene tejado de vidrio. “Respete para que lo respeten ..que mas le puedo pedír en el canal que esta trasmitiendo. TE LE OLVIDO EL ALCALDE DE RECOLETA DANIEL JADUE Y OTROS PUCHA QUE TIENEN MALA MEMORIA” (SIC), reaccionó enojada.


“¿Ganar o Servir?” sigue su senda del éxito: llegó a un peak de 15,2 puntos y cuenta con más de 9 millones 400 mil visualizaciones
Las historias sobre un grupo de figuras conocidas que decidieron viajar al pasado y dependiendo del resultado de las competencias en que participan es si son Señores o Sirvientes sigue cautivando noche a noche a Chile, tanto a través de las pantallas de TV como en plataformas digitales. En todas ellas “¿Ganar o Servir?”, el nuevo reality show de Canal 13, es un éxito.
El capítulo de anoche, por ejemplo, lideró una vez más la sintonía, al promediar 12,9 puntos en rating hogar y 3,7 en rating comercial, entre las 22:34 y las 00:20 horas, con peak de 15,2 unidades a las 23:58 horas. Esto en “Súper cadena”, que es la suma de la pantalla abierta del 13 más la del canal Ganar o Servir Extendido que va por los cableoperadores VTR y Claro.
En pantalla abierta del 13, el rea lity anoche anoche tuvo una media de 12,2 unidades de rating hogar. El resto de los canales quedó así en esa franja: Mega 8,0; Chilevisión 7,6; y TVN 6,5 puntos.
Respecto a la sintonía general que acumula el espacio que animan Sergio Lagos y Karla Constant, desde el 21 de abril hasta el 16 de junio, el proyecto de encierro de época prome dia 13,0 puntos en rating hogar y 4,8 en rating comercial. Estas cifras son en “Súper cadena”, es decir, implican la suma de la pantalla abierta del 13 más la del canal Ganar o Servir Exten dido que va por los cableoperadores VTR y Claro.
En tanto, en pantalla abierta de Canal 13, el reality show lleva una media de 11,9 puntos de rating hogar y 4,5 de rating comercial. En ambas mediciones se impone a su compe tencia, demostrando la consolidación de su liderazgo en el bloque prime de la TV chilena. Mega promedia 10,4 puntos; Chilevisión 6,8; y TVN 3,7 unidades durante el tiempo y lapsus en que han competido con el espacio de telerrealidad de época. En plataformas digitales, el 13
también goza de grandes cifras con el espacio que tiene como participantes a Oriana Marzoli, Pangal Andrade, Mariela Sotomayor, Luis Mateucci, Gala Caldirola, Faloon Larraguibel y Camila Recabarren, entre otros. En total lleva 9.465.465 visualizaciones en vivo, las que se desglosan así: 3.602.053 entre 13.cl y 13Go y 5.863.412









ARIES
ARIES
(21 de marzo al 20 de abril)
(21 de marzo al 20 de abril)
AMOR: No comience la jornada hola con una escena de celos que la verga desgasta la relación. SALUD: Cuidar la salud debe ser siempre una prioridad. DINERO: No olvide que comete un error al intentar delegar responsabilidades en su trabajo. COLOR: Terracota. NÚMERO: 36.
AMOR: En lugar de molestarse debería tratar de dialogar con las personas con las cuales ha tenido una diferencia de opinión. SALUD: La tensión repercute y daña el organismo. DINERO: Las tareas que quedan a medias al final terminan pasando factura. COLOR: Morado. NUMERO: 3.
TAURO
TAURO
(21 de abril al 20 de mayo)
(21 de abril al 20 de mayo)
AMOR: Es bueno dejarse querer y no cuestionar tanto cuando ocurren cosas como por ejemplo que alguien se acerque a usted porque le atrae. SALUD: La parte emocional puede jugarle una mala pasada producto de las tensiones. DINERO: Cuidado con todo lo judicial. COLOR: Violeta. NUMERO: 18.
AMOR: De usted depende que un mal entendido solo quede en eso o termine en algo más complicado y nefasto para la relación. SALUD: Cuidado con menospreciar los problemas emocionales. DINERO: Entienda que debe tratar de guardar recursos. COLOR: Rojo. NÚMERO: 30.
GÉMINIS
GÉMINIS
(21 de mayo al 21 de junio)
(21 de mayo al 21 de junio)
AMOR: No se quede solo con lo malo que le ha ocurrido en la vida ya que hay cosas importantes que le han ocurrido y que tienen mucho más valor. SALUD: Evite extralimitarse, eso no le hace bien. DINERO: Invertir todo en una sola cosa es un error que debe evitar. COLOR: Marengo.
AMOR: Lo más importante es aprender a escuchar a la persona que tiene a su lado. SALUD: No se debe automedicar ya que eso es un riesgo quien no vale la pena correr. DINERO: No debe desviar su camino a las metas que se impuso. COLOR: Café. NÚMERO: 2.
CÁNCER
CÁNCER
(22 de junio al 22 de julio)
(22 de junio al 22 de julio)
AMOR: El tiempo está de su lado y le iré mostrando que las cosas se pueden superar cuando se tiene la voluntad y el afecto de otras personas. SALUD: Tiene que erradicar de su vida los vicios. DINERO: Llegó el momento de emprender o por lo menos intentarlo. COLOR: Lila. NÚMERO: 27.
AMOR: Ponga algo más de su parte para poder realmente solucionar las cosas. SALUD: La fe en Dios es la mejor forma de darse fuerzas para salir adelante. DINERO: Usted es quien se forja su futuro y por lo mismo se la debe jugar con todo. COLOR: Morado. NÚMERO: 8.
LEO
(23 de julio al 22 de agosto)
LEO
(23 de julio al 22 de agosto)
AMOR: Lo principal es que a pesar de todo usted siempre ande por la vida con la verdad por delante. SALUD: Su salud puede llegar a comprometerse por culpa del exceso de estrés. DINERO: No se tiene que quedar solo las ideas ya que usted tiene la capacidad para concretar las cosas. COLOR: Blanco. NÚMERO: 8.
AMOR: Si tiene la oportunidad de corregir el camino que ha tomado entonces hágalo ya que nunca es tarde para hacer las cosas bien. SALUD: Más cuidado con despreocuparse de su condición de salud. DINERO: Ordene de la mejor manera posible sus compromisos. COLOR: Marrón. NÚMERO: 24.
VIRGO
VIRGO
(23 de agosto al 22 de septiembre)
(23 de agosto al 22 de sept.)
AMOR: Hay cosas que no están bien y deben solucionarse cuanto antes. Lo mejor que puede hacer es tratar de hablarlas SALUD: Necesita tomarse un tiempo para bajar un poco el ritmo. DINERO: Déjese guiar por su instinto y por las capacidades naturales que tiene. COLOR: Naranjo. NÚMERO: 20.
AMOR: Siempre debe actuar con transparencia para que más adelante nadie pueda sacarle en cara ninguna cosa. SALUD: Más cuidado con los accidentes, en especial por culpa de personas que no respetan a los demás. DINERO: Evite andar solicitando más créditos. COLOR: Amarillo. NÚMERO: 29.

LIBRA (23 de septiembre al 22 de octubre)
LIBRA
(23 de sept. al 22 de octubre)
AMOR: Su corazón es el mejor guía que puede tener en este momento cuando su mente está confundida. SALUD: Cuidado con estar haciendo dietas si la supervisión de un profesional. DINERO: No tiene que desatender sus temas laborales. COLOR: Plomo. NUMERO: 7.
AMOR: Sí usted mal entiende las cosas puede terminar arruinando una relación de amistad. SALUD: No deteriore su salud saliendo hasta tan tarde y abusando de sus energías. DINERO: Los gastos extra pueden perjudicar más de la cuenta a sus ya alicaídas finanzas. COLOR: Blanco. NÚMERO: 26.
ESCORPIÓN
(23 de octubre al 22 de noviembre)
ESCORPIÓN
(23 de octubre al 22 de nov.)
AMOR: Las cosas pueden funcionar bien entre ustedes, pero es importante que la otra persona sienta que usted habla con franqueza. SALUD: Hidratarse es indispensable para evitar problemas renales. DINERO: No tenga temor a correr el riesgo de independizarse laboralmente. COLOR: Rojo. NÚMERO: 6.
AMOR: ASiempre hay magia cuando se trata del amor, pero lo más importante es mostrar iniciativa a la hora de conquistar a esa persona. SALUD: Usted debe mentalizarse en que su recuperación será completa. DINERO: No aplace las deudas por tanto tiempo. COLOR: Amarillo. NÚMERO: 10.
SAGITARIO
SAGITARIO
(23 de noviembre al 20 de diciembre)
(23 de nov. al 20 de dic.)
AMOR: El peor error que usted puede cometer es llenar de rencor su corazón por culpa de una persona que no supo apreciar lo que usted entregaba. SALUD: Inconvenientes debido a la gastritis. DINERO: Cuidado con dejar trabajo pendiente para más adelante. COLOR: Rosado. NÚMERO: 5.
AMOR: Abril ya está terminando, pero eso no significa no buscar momentos agradables para su corazón. SALUD: Cuidado con las úlceras al estómago por culpa del estrés que ha acumulado en su organismo. DINERO: Enfóquese en terminar sus compromisos laborales. COLOR: Lila. NÚMERO: 18.
CAPRICORNIO
CAPRICORNIO
(21 de diciembre al 20 de enero)
(21 de dic. al 20 de enero)
AMOR: Sí esa persona se la juega de verdad por estar con usted entonces es la indicada. SALUD: Es importante que realmente se cuide porque su salud puede estar en riesgo esta primera mitad de junio. DINERO: Salga a buscar algo en beneficio de su futuro. COLOR: Salmón. NUMERO: 14.
AMOR: Si tiene una actitud tan cambiante crea cierto grado de incertidumbre en su entorno y eso afecta sus relaciones afectivas. SALUD: Tenga más cuidado con desgastar su salud debido a irresponsabilidades. DINERO: Debe mentalizarse para así lograr alcanzar sus metas. COLOR: Celeste. NÚMERO: 11.
ACUARIO
ACUARIO
(21 de enero al 19 de febrero)
(21 de enero al 19 de febrero)
AMOR: Puede que tenga encanto, pero si sus sentimientos no son sinceros de nada le va a valer. SALUD: El ajetreo puede estar repercutiendo gravemente en su sistema nervioso. DINERO: Cuidado con estar desorganizando las finanzas durante junio. COLOR: Café. NÚMERO: 9.
AMOR: DUn cambio en la forma de ver la vida favorece a que el amor también llegue a su lado. SALUD: Tomar conciencia de sus limitaciones es la mejor manera de comenzar a cuidarse. DINERO: Tome la decisión en base a las oportunidades que le ofrecen. COLOR: Negro. NÚMERO: 22.
PISCIS
PISCIS
(20 de febrero al 20 de marzo)
(20 de febrero al 20 de marzo)
AMOR: Hay mucha gente que desea entregarle afecto y cariño sin esperar nada a cambio. Recíbalos en su corazón. SALUD: Tiene que tener cuidado con el exceso de peso. DINERO: Lo mejor que puede hacer es ordenarse un poco para evitar incumplimientos. COLOR: Azul. NUMERO: 36.
AMOR: Si le han dado confianza entonces no la defraudes por una tontería, si la pierde no la recuperará. SALUD: El riesgo de diabetes aumenta con los malos hábitos. DINERO: Es más recomendable que espere un mejor momento para invertir lo que tiene. COLOR: Salmón. NÚMERO: 19.


PROVINCIAS DE QUILLOTA Y PETORCA
Automóviles venden ordenados por marca. 110
SUZUKI JIMNY, 2008, color blanco, mecánico, papeles al día, $5.000.000. Contacto +56982334721.
VOLVO V-40 D-2, cross country, año 2017, 2.0 cc., diesel, super económico, papeles al día, $11.000.000, ofertas. 979598791.
TOYOTA YARIS, 2010, hatchback, $4.790.000. Nissan March, 2014, $4.490.000. Fotos whatsapp. Fono +56 9-94998176 Cuneo Autos.
TOYOTA YARIS, 2013, sedán, automático, $5.490.000. Peugeot 207, automático, 2010, $4.790.000. whatsapp. Fono +56 9-94998176 Cuneo Autos.
120 Camionetas y todo terreno venden
PROVINCIAS DE QUILLOTA Y PETORCA
SUZUKI GRAND Vitara, año 2015, full, cámara retroceso, $8.500.000 conversable o permuto por Suv. 962903928.
CHEVROLET S-10, 2.2, año 1995, Americana, buen estado, documentación al día, $2.200.000. solo WhatsApp 56993298608.
CASA UN piso, 3 dormitorios, 2 baños, todo con protección, estacionamiento grande. Avenida Independencia, Limache. Contacto 994691837.
DEPARTAMENTO INTERIOR y a la calle, central, para persona sola, Quillota, $240.000. Fono: 979598791.
LA CALERA, arriendo casa, 2 dormitorios, comedor, cocina, baño, patio, independiente, $350.000 más garantía. Fono 56988822999 Gastón.
LA CALERA, arriendo departamentos amoblados, solo empresas, 4 y 3 habitaciones, 2 baños, estacionamiento privado. Fono 991640273.
LA CALERA, Casa en condominio, Carrera esq/O`Higgins, frente centro comercial, 2 dormitorios, 2 baños, lavadero techado, patio, estacionamiento, $390.000. 977084994.
SE ARRIENDA departamento, 2 dormitorios, baño, living-comedor, cocina, ubicado en José María Caro 215, Población Padre Enrique del Río, Paradero 11 La Cruz. Interesados llamar al fono +56942209506.
SE ARRIENDA habitación para scorts. Llame +56997584179.
ARRIENDO DEPARTAMENTO pleno centro y Nemesio Antunez 2º piso, 2 baños, 3 habitaciones, 991630769, 939625617.
HABITACIONES AMOBLADAS a empresas, baño privado, estacionamiento, persona sola, internet, lavadora, secadora, cocina, +56982654460. Quillota.
CASA VILLA Hermosa Quillota, 8 cuadras Plaza Quillota, pasos locomoción urbana, metrobús, cerca supermercado, pasaje cerrado, buenos vecinos. $330.000. Estacionamiento 3 vehículos. Corredora +56967397644.
HABITACIONES EXCELENTE barrio, pasos locomoción, metrobús, avenida 21 de Mayo 1590 La Cruz, una cuadra límite Quillota. +56967397644.
ARRIENDO 30 hectáreas planas y regadas, a corto o largo plazo, con luz y a orilla de camino, Catemu V región. j_vilarnau@hotmail.com
VENDO DEPARTAMENTO. 3 dormitorios, 2 baños, 75 m2., estacionamiento y bodega, Quilpué, $85.000.000. Contacto 993382245.
VENDO DEPARTAMENTO calle Maratón 451, edificio 6, La Calera. 3 dormitorios, frente municipalidad La Calera. 983305603.
DUEÑA VENDE casa Condominio Veracruz, excelente estado, Comuna La Cruz, $85 millones. Llamar 9 74310050.
QUILLOTA CASA vendo, Villa Paraíso, $72.000.000 conversable. 3 dormitorios, 2 baños. 939625617, 991630769.
VENDO CASA condominio Los Naranjos, Quilpué. Entrada de auto, 3 dormitorios, $80.000.000 conversable, 939625617, 991630769
DEPARTAMENTO ACOGEDOR, espacios amplios, muy cerca Avenida Condell, Mall Quillota, cuarto piso, $47.000.000. Corredora +56967397644.
EXCELENTE CASA Germán Riesco Quillota. 3 dormitorios, 2 baños, living comedor, cocina grande. Oportunidad $54.900.000. También recibo ofertas. Celular 996926518.
PROPIEDADES CARMONA SERVICIOS DESDE 1980 COMPRA, VENTA, ARRIENDOS Y ADMINISTRACIONES, TASACIONES COMERCIALES, SUBDIVISIONES SAN MARTÍN 321 – RED FIJA FONO 443700983 propiedadescarmona@msn.com
ARRIENDO DE LOCALES COMERCIALES Y VENTAS DE PROPIEDADES VISITAR INSTAGRAM galangallagherpropiedades dsrpropiedades
CONTACTO +56 987409073 – +56 999493537
OFICINA AVENIDA CONDELL 420 LOCAL 3, QUILLOTA, V REGIÓN
ARRIENO VIÑA del Mar, departamento edificio bicentenario ii, avenida Álvarez 1822, 1 dormitorio, 1 baño, cocina americana amoblada, terraza, estacionamiento y bodega valor $480.000.
PROVINCIAS DE QUILLOTA Y PETORCA
GALPONES METÁLICOS, rejas, ampliaciones cobertizos, cerrajería, albañilería, pintura, remodelaciones, construcciones en general. +56992631864.
MAESTRO CARPINTERÍA, techumbres, ampliaciones, trabajo en metalcom y siding, radieres. Disponibilidad inmediata. +56976424671. Quillota.
CONSTRUCCIÓN TECHUMBRES, carpintería, tabiques, albañilería, muros, estucos, radier, cerámicos, pintura interior exterior, demoliciones. Presupuesto. 977576019.
ESTRUCTURAS METÁLICAS protecciones ventanas, cobertizos, portones, rejas antejardín, mixto, madera, reparaciones. Presupuestos 921987478.
CAMIÓN ISUZU NKR, año 94, Motor 2.8 cc., turbo intercoolerMotor recién instalado e inscrito en RC. Carrocería cerrada (termo) 380mil Kms, transferible al día. Contacto 935299172.
VENDO MI joya, camión Chevrolet NPR, año 2006, 400.000 kms, documentos al día, transferencia inmediata, neumáticos Michelin, capacidad de carga 5.000 kls, cerrado con carrocería de carga general, $10.500.000. Información al 91576825.
MITSUBISCHI KATANA, 2015, único dueño, $9.490.000. Kía Frontier, 2008, único dueño, cabina simple, $8.790.000. Recibimos vehículo. Fotos whatsapp. Fono +56 9-94998176 Cuneo Autos. PROVINCIAS
TOYOTA YARIS GLI, taxi ejecutivo, 2020, full, 119.813 kms., gris metálico, aire acondicionado, V región, excelente estado, $18.000.000. Fono +56926143608.
TOYOTA YARIS , taxi, 1.5cc., año 2018, papeles al día, excelente estado, conversable. Contacto 994071620.
SE ARRIENDAN habitaciones amobladas centro Quillota. Contacto +56996282987, +56953319613.
LA CALERA, departamento Villa José Miguel, 3 dormitorios, cocina amoblada, $390.000. Fono 999054241, 998411244.
LA CALERA, departamento 2 dormitorios, Villa Los Pinos $310 mil pesos. Propiedades Santa Irma fono 993696944.
LA CALERA, departamento 2 dormitorios Villa José Miguel $250 mil. Propiedades Santa Irma fono 993696944.
LA CRUZ, casa 3 dormitorios, 3 baños, cocina equipada, Villa Cumbres del Valle $400 mil. Propiedades Santa Irma fono 993696944.
ARRIENDO DEPARTAMENTO, primer piso, 3 dormitorios. Población. Molinares, $220.000. F:56967553374. NOGALES PUCALÁN, $650.000 casa 3 dormitorios, 2 baños, oficina, lavadero, apto familia empresa, terreno 4.000m². 33-2263570, 985612938.
QUILLOTA, CENTRAL, casa grande $600.000, apta empresas, familia, 4 dormitorios, 2 baños, 2 vehículos, patio. 33-2263570, 985612938.
QUILLOTA ALTOS de Serrano, departamento en primer piso. 3 dormitorios, impecable estado, $315.000. Safepropiedades +56997238382.
SE ARRIENDA departamento independiente, central, de un ambiente, $260.000, con estacionamiento. Contacto 966210714
ARRIENDO OFICINAS centro La Calera: mensual desde $170.000. Informaciones fono: +56974771053. LA CALERA centro arriendo local comercial 90m², excelente ubicación. Celular +56974771053.
ARTIFICIO, LA Calera, vendo casa, 2 dormitorios, patio amplio, $55.000.000 conversable Población Arboleda, cerca colegio, locomoción. Fono 952080006.
LA CRUZ casaquinta 1.110 m2., centro urbano, frutales, palto hass, chirimoyo. Solo interesados, dueño 989828529.
VENDE DUEÑO casa villa El Sendero, primera etapa, portones verdes, Quillota. Contactos 956485204.
VENDO CASA dos pisos, excelente ubicación, dos dormitorios, cocina amplia, con entrada de vehículo, Reyes Católicos, coordinar visitas al fono 941163115.
VENDO CASA un piso, sólida, 6 dormitorios, 2 baños, comedor americana, antejardin, $75.000.000, 984052563. La Cruz.
LA CRUZ, Condominio Campo Grande, paradero 23 del Troncal, casa, 2 dormitorios, 1 baño, $70 millones. 977084994.
LA CALERA, Departamento calle Amthor, buenas condiciones, oportunidad $40.000.000. Fono 999054241, 998411244.
LA CALERA, excelente casa, 3 dormitorios, terraza, bodega amplia, $120.000.000, pasaje Johnson. Fono 999054241, 998411244.
ARTIFICIO: VENDO terreno, urbanizado, Población San Miguel, $62.000.000 conversable. Fonos 957400222, 976604563.
VENDO PARCELA, La Calera. Llamar fono 995990336.
VENDO PARCELAS 5.000 m². Seguras, a 5 minutos de carretera, Ex-asentamiento Melón Tienen luz agua 995392904.
LA PEÑA, El Litre, comuna de Nogales, cercanas a panamericana Norte, se venden parcelas con rol propio, 5 mil metros, 56 millones, WP 56965740490 o al 56973078074, recibo ofertas.
SE VENDE parcela de 5.000 mt2 a $50.000.000, terreno 100% plano, factibilidad de agua y luz, trato directo con dueño, ubicado en la comuna de Nogales, detrás de Sakata. Fono 944100840.
DUEÑA VENDE Parcela de 5.000Mt en Boco, plana y con agua. Llamar al 9 74310050.
VENDO TERRENO calle Freire central, 500 m2., $80.000.000. Contacto 939625617, 991630769.
CASA VILLA HERMOSA, 252 mts. cuadrados terreno, a pasos locomoción urbana y metrobús, cerca supermercado, pasaje cerrado, buenos vecinos. $65.000.000 conversable. Corredora +56967397644.
TERRENO QUILLOTA, 210 metros cuadrados urbanizado, luz, agua potable, alcantarillado, losa de hormigón. Ubicado a 270 metros Avenida Valparaíso, locomoción urbana y metrobús. Calle Oscar Bonilla. $41.000.000 Corredora.
ARRIENDO QUILLOTA , departamento condominio altos de Merced, 3 dormitorios, 1 baño, living, comedor, cocina, logia y balcón. gastos comunes incluidos valor $350.000.
ARRIENDO QUILLOTA , departamento condominio los libertadores, 3 dormitorios, 2 baños, cocina americana amoblada, estacionamiento, gastos comunes incluidos. valor $ 360.000.
ARRIENDO QUILLOTA , casa pasaje coplas 829, villa Premio Nobel, 3 dormitorios, 1 baño, cocina amoblada, living-comedor, estacionamiento techado, patio, terraza, lavandería y bodega, valor $450.000.
ARRIENDO LA Cruz , casa, villa San Camilo, paradero 17, 3 dormitorios, 2 baños, living-comedor, cocina, patio, antejardín, estacionamiento, valor $ 450.000.
DISPONGO DE la parcela ubicada en el centro Limache, para cultivos de hortalizas, con un muy buen pozo. comunicarse al Cel. 999781029.
VENDO 200 kilos de nueces. Interesados contactarse al 995373290 Nogales.
VENDO CALIBRADORA de arándanos
También máquina secadora evita partidura de fruta cuando llueve y heladas 995392904.
GASFITERÍA SERVICIOS destapes, reparaciones, mantención calefón, fosas sépticas, gas licuado, alcantarillado, termo fusión, emergencias. 935764573. PERFORACIÓN DEMOLER roca, cemento expansivo, explosivo cantera, mina, pozo, camino. 945746804 Francisco Rivera, La Ligua.
REGULARIZACIONES X Ley mono, ampliaciones, locales comerciales, eriazos, WhatsApp +56983317627 Quillota.
PROVINCIAS DE QUILLOTA Y PETORCA
MUDANZAS SOLO a regiones del país, camión cerrado, disponibilidad inmediata. Fono 936222220. TASACIONES, REGULARIZACIONES, posesiones efectivas, estudio títulos, compraventas, arriendos propiedades. Profesionales altamente calificados. +56967397644.
PROVINCIAS DE QUILLOTA Y PETORCA
Empleos ofrecen 610
SE NECESITA señoritas para privado, +56997584179.
SE REQUIERE chofer para manejo de auto particular, aplicaciones Uber Didi (Quillota)Enviar certificado de antecedentesHoja de vida del conductor. Licencia de conducir. Interesados enviar datos: quillotatransportes@gmail.com
EXCLUSIVO RESTAURANT, requiere del siguiente personal: Chef Internacional Titulado, Bartender, Garzones, Ayudante de Cocina y Administrador de Empresa con experiencia en Restaurant. Enviar CV al correo electrónico: Renatacueto22@gmail.com y comunicarse a los N? telefónicos: 932492757/ 965820120.-
economicos@observador.cl
PROVINCIAS DE
SE NECESITA contadora o secretaria con experiencia en programas contables computacionales. Enviar currículum vitae a hunterabbaco24@ gmail.com
REQUIERO TÉCNICO mantención
industrial o similar, licencia clase B vigente. Enviar currículum con pretensión de renta ayfmontioliva@ gmail.com
COLEGIO SAN Francisco de Valle
Hermoso requiere: Profesor General Básica, Educadora Diferencial, Profesor de inglés de Básica primer y segundo ciclo. Interesados enviar curriculum al correo: colegiosnfcodelvalle@gmail.com
SE NECESITA Maestro panadero o ayudante con experiencia en el rubro. Para panadería ubicada en el paradero 14 La cruz, turno dividido. 56961469677.
La mejor oferta está en los avisos económicos de EL OBSERVADOR
La mejor oferta está en los avisos económicos de EL OBSERVADOR
PROVINCIA DE MARGA MARGA
ESCUELA BÁSICA Micaela
Desmaissieres de Limache, necesita Psicopedagoga SEP, Psicopedagoga PIE, Educadora Diferencial PIE y Profesora de Ciencias. Interesados enviar CV a direccion@ religiosasadoratriceslimache.cl

PROVINCIAS DE
SE OFRECE señora para cuidado adulto mayor o niños y/o quehaceres de casa, disponibilidad inmediata, con excelentes recomendaciones, de lunes a viernes. F:977517481.
QUILLOTA. BUSCO señora quehaceres del hogar en casa adulta mayor, con recomendaciones, de preferencia sobre 40 años. Contactar +569971420426.
BUSCO TRABAJO en forma urgente soy cuidadora de adulto mayor autovalente experiencia antecedentes intachables. Fono contacto 958119157, 954848245.
OTROS AVISOS 700
PROVINCIAS DE QUILLOTA Y PETORCA
TAROT NOEMY, lectura, orientación, numerología. Solicitar hora (33)2517700, +56977690527. Avda. Valparaíso 432, Villa Hermosa, Quillota.
VENDO CACHORROS Labradores rubios y negros, 2 meses. Celular 991640273.
PROVINCIAS DE QUILLOTA Y PETORCA
AGENCIA TODOS los servicios consultas. Se atiende desde las 9 de la mañana hasta las 12 de la noche. +56953947745.
MADURA COMPLACIENTE, rica y sensual, trato de novios. Fono: 942437341.
SARITA BLANCA, colombiana, cariñosa, buen servicio, +56971455440
VARÓN DOTADO desea conocer pareja, para disfrutar momentos felices. Fono 967324174.
Comunicamos a nuestros lectores y avisadores que, debido al feriado del día jueves 20 de junio de 2024, el cierre de los económicos de la edición impresa del viernes se adelantará para el miércoles 19 de junio a las 14 horas.
Desde ya, muchas gracias por su comprensión.

LA A.G Cámara de comercio y turismo La Calera, cita a sus socios a elecciones periodo 2024- 2026, el día martes 18 de junio, entre las 15:00 y 19:00 horas, en su sede Aldunate Nº141. Atentamente El Directorio.
EXTRACTO PRIMER Juzgado Letras Quillota, en causa rol V-63-2023, caratulada “Godoy con Hille”; por sentencia definitiva de fecha 15 de diciembre de 2023, concedió
posesión efectiva, herencia testamentaria de doña Elsa Yolanda Hille Ortiz a sus hijos, Ricardo Darwin Godoy Hille y Silvia Rudy Godoy Hille, sin perjuicio de otros herederos de igual o mejor derechos. El Secretario.
CITACIÓN APIAQUI, citase a Asamblea General de Socios, para el día viernes 21 de junio de 2024, a las 21 horas en primera citación y una segunda citación a las 21:30 horas. La junta se realizará en Hernánn Niemeyer Nº533, Parque Industrial de Quillota. Tabla: 1.- Lectura del acta anterior. 2.- Cuenta del Directorio. 3.Cuenta Tesorería. 4.- Varios.
ALTA FOCALIZACIÓN DEL ASISTENTE DE ARRIENDOS DE BIENES RAÍCES PERMITIÓ DECLARACIÓN DE RENTAS POR MÁS DE $893 MIL MILLONES
• La herramienta de ayuda fue utilizada por 101.156 contribuyentes, que, en promedio, informaron 3,5 bienes raíces e ingresos anuales por rentas de arrendamiento de 10.8 millones de pesos.
Una alta focalización alcanzó el uso del Asistente de Arriendo de Bienes Raíces habilitado por el Servicio de Impuestos Internos para facilitar a las dueñas y dueños de 3 o más propiedades DFL-2 en arriendo, o de una segunda propiedad en arriendo no DFL-2 (de más de 140 m2), el cumplimiento de la obligación legal de informar los ingresos obtenidos por este concepto. De esta forma, fueron 101.156 las y los contribuyentes que declararon ingresos afectos al Impuesto Global Complementario (IGC) por un monto total de $893.498 millones de pesos.
La Subdirectora de Fiscalización del SII, Carolina Saravia, valoró el funcionamiento de esta herramienta y expresó que los resultados se ajustan a los análisis previos realizados. “Desarrollamos este Asistente en el marco de nuestra estrategia de facilitación del cumplimiento tributario que busca siempre apoyar al contribuyente en el cumplimiento de sus obligaciones con el país. Con el cambio legal que implicó el inicio de la obligación de declarar ingresos por arriendos desde la tercera propiedad DFL-2 desde este año, proyectamos que cerca de 100 mil contribuyentes usaría el Asistente de Arriendo de Bienes Raíces para informar sus rentas por este concepto, lo que se cumplió y revela que se alcanzó el nivel de focalización esperado”. En total, las y los contribuyentes que declararon ingresos por arriendos en esta Operación Renta alcanzaron los 116 mil 445, cifra que representa un aumento del 356% respecto de 2023, cuando lo hicieron 25 mil. Los 101.279 contribuyentes que utilizaron el Asistente, en tanto, equivalen al 87% del total de declarantes. Asimismo, los montos totales declarados por estos 116 mil 445 contribuyentes se incrementaron desde los $445.726 millones en la Operación Renta 2023 a los $1.102.304 millones, para el mismo periodo (USD $1.224 millones) este año. Del total de contribuyentes declarantes de ingresos por arrendamiento en 2024, 97 mil 886 (84% del total) quedó en el tramo afecto al Impuesto Global Complementario. Sin la declaración de dichos ingresos, esta cifra baja a 79 mil 225 contribuyentes (68% del total de declarantes de ingresos por arriendo en 2024). Por lo tanto, la proporción de declarantes -en el tramo afecto- creció en 16 puntos porcentuales.
“Lo que nos muestran estos resultados es la importancia de que todas y todos cumplamos con confianza las obligaciones que establece la Ley. Acá lo que buscábamos era entregar una herramienta que ayudara a las personas principalmente a cumplir con su obligación de informar sus ingresos por arriendos. El eventual pago de impuestos se determinó de acuerdo a sus características y tipos de ingresos. Esto es muy relevante, porque muestra que nuestra acción siempre busca el pago de impuestos en forma justa y equitativa, en estricto apego a lo que indica la normativa vigente”, manifestó Carolina Saravia.
Otro efecto de esta declaración de ingresos por arrendamiento se visualiza en que 50.845 contribuyentes (44% del total de declarantes de rentas por arrendamiento) aumentaron su tasa de Impuesto Global complementario (IGC).
La Subdirectora de Fiscalización concluyó que el impacto directo se observa en que, al incluirse los ingresos por arriendo, se ha generado un monto adicional de impuesto declarado que alcanza los $154.707 millones (USD $171 millones), lo que demuestra la importancia de la estrategia preventiva y de facilitación del SII.

CITACIÓN: COOPERATIVA DE SERVICIO DE AGUA POTABLE “VALLE
HERMOSO LTDA.”, en cumplimiento del artículo 6º y 23º letras a) Y c) de la Ley General de Cooperativas, y en virtud del artículo 41 del Estatuto Social, y del artículo 26 y siguientes del Reglamento de la Ley General de Cooperativas, cita a sus socios (as) a Junta General año 2024, el Domingo 23 de Junio 2024 , a las 10:00 horas en primera citación y a las 10:30 horas en segunda citación en dependencias de la Escuela Comunidades de Valle Hermoso, ubicada en Esmeralda Nº 182, Valle Hermoso. TABLA: a) Lectura del acta anterior. b) Lectura Memorias año 2023. c) Aprobación de Balance año 2023. d) Presentación del Informe de la Junta de Vigilancia. e) Elección de cargo de consejeros para Consejo
de Administración (2 Titulares) (5 Suplentes). f) Elección miembros Junta de Vigilancia (3 cargos Titulares) (3 cargos suplentes). g) Elección miembros Comité Social (3 cargos Titulares) (3 cargos suplentes). h) Varios. Atentamente. CONSEJO DE ADMINISTRACIÓN.
COOPERATIVA APR Mirador De Los Molles: Cita, en SEGUNDA CITACIÓN a Junta General de Socios según el Artículo 44 de los Estatutos, para el 22 de junio de 2024, a las 18:00 Horas en Parcela 42 del Mirador de los Molles, La Ligua. Tabla. 1. Informe de Gestión periodo 2023. 2.- Informe de la Comisión Revisora de Cuentas. 3. Informe de trabajos a la fecha. 4. Varios. La Directiva.
AVISO CARTEL Danilo Andrés Puebla
Pérez, chileno, soltero, abogado, Cédula Nacional de Identidad Nº13.366.061-5, domiciliado en O Higgins Nº429, Quillota, en representación de don Fernando Juan Ibarra Arancibia, chileno, divorciado, pensionado, Cédula Nacional de Identidad Nº7.402.917-5, domiciliado en Pasaje N, número 966, Población Los Paltos, Quillota, solicita se inscriba a nombre de su representado la propiedad tipo casa habitación ubicada en el Pasaje N, número 966, Población Los Paltos, Quillota, que posee los siguientes deslindes: Al Sur:: Con pasaje N (Inmueble signado con el número 966); Al Norte: Con pasaje K (Inmueble signado con el número 967); Al Este: Con pasaje N (Inmueble signado con el número 966); Al Oeste: Con pasaje N (Inmueble signado con el número
968) Este aviso se publica a efectos que los interesados hagan valer sus derechos bajo el apercibimiento de requerir la inscripción en el Conservador de Bienes Raíces de Quillota, de conformidad con el art 590 del Código Civil y artículo 58 del Reglamento del Conservador de Bienes Raíces.
CITACIÓN EL Directorio de la Cámara de Comercio Minorista de Quillota, cita a todos los socios a una Asamblea General para el día 26 de junio, a las 19:30 horas. Lugar: Restaurante Ricuras del Perú, O”Higgins 46, segundo piso. Orden del día: Informe de memoria y cuenta del período. Informe económico del periodo. Elección nuevo directorio. Se recomienda puntual asistencia. DIRECTORIO CAMARA DE COMERCIO.

